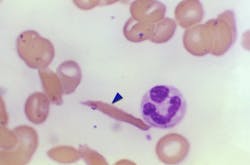
65773b45abdedf001e6e56f6 17524 65773b45abdedf001e6e56f6 17524

The U.S. Food and Drug Administration approved two milestone treatments, Casgevy and Lyfgenia, representing the first cell-based gene therapies for the treatment of sickle cell disease (SCD) in patients 12 years and older.
Casgevy, a cell-based gene therapy, is approved for the treatment of sickle cell disease in patients 12 years of age and older with recurrent vaso-occlusive crises. Casgevy is of the first FDA-approved therapies utilizing CRISPR/Cas9, a type of genome editing technology. Patients’ hematopoietic (blood) stem cells are modified by genome editing using CRISPR/Cas9 technology.
CRISPR/Cas9 can be directed to cut DNA in targeted areas, enabling the ability to accurately edit (remove, add, or replace) DNA where it was cut. The modified blood stem cells are transplanted back into the patient where they engraft (attach and multiply) within the bone marrow and increase the production of fetal hemoglobin (HbF), a type of hemoglobin that facilitates oxygen delivery. In patients with sickle cell disease, increased levels of HbF prevent the sickling of red blood cells.
Lyfgenia is a cell-based gene therapy. Lyfgenia uses a lentiviral vector (gene delivery vehicle) for genetic modification and is approved for the treatment of patients 12 years of age and older with sickle cell disease and a history of vaso-occlusive events. With Lyfgenia, the patient’s blood stem cells are genetically modified to produce HbAT87Q, a gene-therapy derived hemoglobin that functions similarly to hemoglobin A, which is the normal adult hemoglobin produced in persons not affected by sickle cell disease. Red blood cells containing HbAT87Q have a lower risk of sickling and occluding blood flow. These modified stem cells are then delivered to the patient.
Both products are made from the patients’ own blood stem cells, which are modified, and are given back as a one-time, single-dose infusion as part of a hematopoietic (blood) stem cell transplant. Prior to treatment, a patients’ own stem cells are collected, and then the patient must undergo myeloablative conditioning (high-dose chemotherapy), a process that removes cells from the bone marrow so they can be replaced with the modified cells in Casgevy and Lyfgenia. Patients who received Casgevy or Lyfgenia will be followed in a long-term study to evaluate each product’s safety and effectiveness.
The safety and effectiveness of Casgevy were evaluated in an ongoing single-arm, multi-center trial in adult and adolescent patients with SCD. Patients had a history of at least two protocol-defined severe VOCs during each of the two years prior to screening. The primary efficacy outcome was freedom from severe VOC episodes for at least 12 consecutive months during the 24-month follow-up period. A total of 44 patients were treated with Casgevy. Of the 31 patients with sufficient follow-up time to be evaluable, 29 (93.5%) achieved this outcome. All treated patients achieved successful engraftment with no patients experiencing graft failure or graft rejection.
The most common side effects were low levels of platelets and white blood cells, mouth sores, nausea, musculoskeletal pain, abdominal pain, vomiting, febrile neutropenia (fever and low white blood cell count), headache and itching.
The safety and effectiveness of Lyfgenia is based on the analysis of data from a single-arm, 24-month multicenter study in patients with sickle cell disease and history of VOEs between the ages of 12- and 50- years old. Effectiveness was evaluated based on complete resolution of VOEs (VOE-CR) between 6 and 18 months after infusion with Lyfgenia. Twenty-eight (88%) of 32 patients achieved VOE-CR during this time period.
The most common side effects included stomatitis (mouth sores of the lips, mouth, and throat), low levels of platelets, white blood cells, and red blood cells, and febrile neutropenia (fever and low white blood cell count), consistent with chemotherapy and underlying disease.